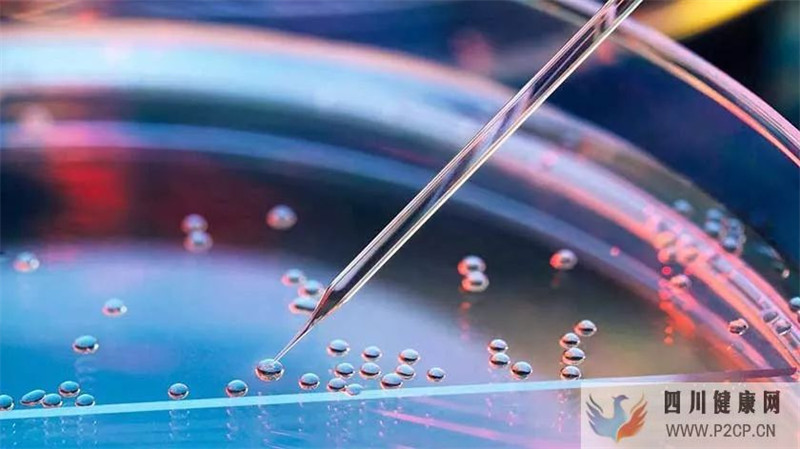
新突破：干细胞疗法五种机制，打破传统治疗糖尿病肾病旧局面(图2)

新突破:干细胞疗法五种机制,打破传统治疗糖尿病肾病旧局面
随着组织工程兴起与不断发展,干细胞凭借其高度自我更新能力及多向分化潜力成为生命科学研究热点。 作为理

随着组织工程兴起与不断发展,干细胞凭借其高度自我更新能力及多向分化潜力成为生命科学研究热点。
作为理想种子细胞,干细胞移植后具有定向趋化特点,其通过迁移至损伤肾组织并且分化为肾脏固有细胞而发挥修复作用,为干预糖尿病肾病,延缓肾脏纤维化进展提供新途径。
打开凤凰新闻,查看更多高清图片
打开凤凰新闻,查看更多高清图片干细胞疗法与传统药物干预糖尿病肾病具明显优势
糖尿病肾病(diabetic nephropathy,DN)是糖尿病(diabetes melIi—tus,DM)肾脏微血管并发症,典型病理改变为肾小球硬化症。
包括遗传因素,肾小球血流动力学改变、糖代谢异常以及众多细胞因子、生长因子、炎性介质等协同作用,这些异常长期存在导致肾小球系膜基质及基底膜合成增加及肾小球系膜基质及基底膜降解减少,最终导致肾小球硬化。
目前我国糖尿病患病率为9.7%,而糖尿病肾病是糖尿病常见慢性微血管副反应,预计2030年全球糖尿病患者将达4.3亿,其中1/3可能发展为糖尿病肾病。
虽然药物在控制血糖水平中有效,但在控制和预防慢性副反应方面未见明显效果,以干细胞为基础干预手段逐渐成为糖尿病肾病良好方法,与单纯药物干预相比具有明显优势。
干细胞疗法五种机制为干预糖尿病肾病提供新思路
干细胞是一种多潜能干细胞,可分化为多种细胞。其干预糖尿病肾病机制有以下五点,这些优势应用为糖尿病肾病干预提供了广阔前景。
1. 分化潜能:干细胞在体外可分化为胰岛素分泌细胞;在体内则可分化为肾脏细胞,且能重建损伤肾脏组织坏死部分。
2. 具有多种效能:包括免疫调节、抑制凋亡、抑制纤维化、抵抗氧化应激、分泌营养因子、增强血管再生等。
3. 高表达:干细胞能够恢复肾病蛋白和跨膜蛋白podocin的表达。
4. 免疫抑制:干细胞可以减少巨噬细胞组织浸润,维持组织平衡以及在损伤阶段释放抗炎症因子。
5. 旁分泌:干细胞能够抑制肾小球基底膜增厚,通过旁分泌肾脏营养因子包括多功能外分泌体保护肾脏,外分泌体还具抗细胞凋亡作用,且能够保护肾小管上皮细胞之间紧密连接;
干细胞还能加强胰岛素分泌,增加胰岛细胞数量,并且增强胰岛素干预敏感性。
干细胞疗法通过糖尿病肾病大鼠试验研究证实效果显著
干细胞在糖尿病肾病大鼠体内能够逆转葡萄糖、胰岛素、血红素加氧酶—1、晚期糖基化终末产物水平,同时干细胞具有调节各种生长因子能力。
如转化生长因子B(transforming growth factorp,TGF—B)、血小板衍生生长因子(platelet—derived growth factor,PDGF)和成纤维细胞生长因子(fibroblast growth factor,FGF)。
干细胞还能够下调肾脏组织单核细胞趋化蛋白—1(monocyte chemotactic protein—1,CP—1)和白细胞介素—8(interleukin—8,IL—8)基因表达。
干细胞移植能够降低血糖水平,且还能改善糖尿病肾病病理症状,可能是因为干细胞能够分泌一系列细胞生长因子,这些生长因子通过旁分泌或者远距分泌能够促进损伤组织血管再生和改善血液循环。
干细胞疗法能够改善糖尿病肾病代谢功能并且降低血糖浓度可能与修复胰岛和肾脏组织结构有关,还可抑制炎症反应或者是逆转这一进程。
干细胞还可以显著抑制糖尿病肾病肾脏纤维化进程,可能机制是其能够抑制TGF一13/Smad3信号通路,降低I型纤溶酶原激活物抑制因子表达,同时减少细胞外基质的集聚,从而平衡纤维蛋白溶解系统抑制纤维化进程。
此外,研究表明,炎症反应是导致糖尿病肾病一个主要致病因素之一,通过观察慢性肾病肾脏功能以及组织学改变证实干细胞抗炎作用对糖尿病肾病有显著改善作用。
干细胞疗法通过糖尿病肾病临床研究证实安全有效
案例分享
1994年至2019年河北省某医院开展61例2型糖尿病伴肾病患者临床研究,运用干细胞疗法干预两周后,结果显示,所有患者在血、尿β2—MC方面及肾功三项均发生显著改变。
最终结论,干细胞疗法干预糖尿病肾病,尤其是早期肾病安全且有效。
综上所述,干细胞疗法在糖尿病肾病干预过程中能够改善蛋白尿、减缓糖尿病肾病进程,达到干预糖尿病肾病目的。随着干细胞疗法机制不断深入研究,干细胞干预糖尿病肾病指日可待,其将为人类生命健康发挥最大价值。





